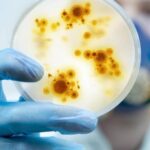

Los gastos por medicamentos pueden resultar altos, sin embargo, es posible ahorrar si se toman medidas preventivas y se aplican algunos trucos efectivos. Debido a que se trata de un rubro que puede generarse de manera imprevista por una enfermedad temporal o ser recurrente cuando existe una condición de salud permanente, es importante tener un plan para no afectar el bolsillo de la familia.
De acuerdo con la Dra. Estefanía Arias, médico de Farmacias Económicas, “muchas personas tienen que abandonar el tratamiento o prefieren no comprar sus recetas cuando los costos son altos, pero esta no es una opción favorable para la salud de las personas, ya que ponen en riesgo su vida; no obstante, existen muchas formas de ahorrar en la compra de medicamentos y de otros aliados del bienestar diario, únicamente se necesita informarse de manera oportuna de todas las facilidades que existen en el mercado. Además, y la más importante recomendación, es la prevención, ya que de esta manera se evitan enfermedades y por ende gastos para su tratamiento”.
Antes de entrar en materia, es fundamental entender la función de los medicamentos. “El ingrediente activo del medicamento ingresa al sistema circulatorio y se transporta en la sangre hacia la zona a tratar. Una vez que el medicamento ha llegado a la parte del cuerpo donde debe actuar, enviará estímulos a las células para producir los efectos deseados. Estos efectos son la estimulación, acelerando las células en la producción de sustancias químicas y la inhibición, disminuyendo la producción de sustancias o las reacciones de las mismas.”, explica la Dra.
- ● Prevenir: La prevención en salud es primordial, ya que al mantenerse sano no es necesario incurrir en gastos por recetas. De todas maneras, esta tarea también requiere de inversión, ya que es importante acudir al médico y realizarse chequeos generales anuales, de todas maneras, su valor no superará los costos de una enfermedad. Esta es la mejor manera para ahorrar en salud en el futuro.
- ● Cambiar a genéricos: Los medicamentos genéricos contienen los mismos componentes que los medicamentos de marca, por lo que generan el mismo efecto en el cuerpo. Tienen la misma dosis, seguridad, eficacia, potencia, estabilidad y calidad, así como su administración y uso. Es recomendable consultar al especialista si es posible cambiar la medicación a un producto genérico.
- ● Organizar la compra: En ocasiones se suelen adquirir los medicamentos o productos de manera individual, esto puede significar un aumento en el costo de la receta. Por ejemplo, comprar pastillas de manera individual suele incrementar el costo, pero si se adquiere por cajas es más conveniente porque se puede acceder a promociones o descuentos. De igual manera, existen implementos de bienestar que cuentan con precios menores cuando se adquieren en promociones o más unidades. Por este motivo, es importante planificar la compra para coincidir con los días de promociones y poder adquirir los productos a buenos precios.
- ● Programas de medicación continua: Algunos medicamentos cuentan con planes de medicación frecuente, sobre todo los relacionados a enfermedades crónicas y catastróficas. Estos planes toman en cuenta el consumo recurrente de los fármacos y ofrecen recompensas a las personas que los necesitan. Para ello, es importante consultar en los establecimientos comerciales si cuentan con este tipo de programas para acogerse a todos los beneficios. Inclusive, suelen brindar una dosis gratis o descuentos después de realizar cierto número de compras de la misma medicina.
- ● Cobertura de seguros: Muchos seguros médicos cuentan con cobertura de un porcentaje del costo de la medicación. En esos casos, el afiliado puede acudir a cualquier establecimiento con la receta, la misma que debe reunir todas las condiciones básicas que exige el seguro y solo tiene que mencionar la compañía a la que está afiliado. La mayoría de farmacias cuentan con un sistema de confirmación en el que los medicamentos solicitados son verificados como autorizados por la compañía de seguros y bajo el plan mantenido por el asegurado, se verifica la validez de la receta y el acceso al medicamento.